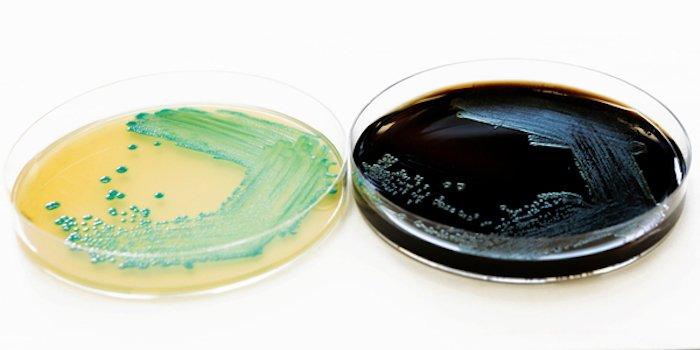

Das Verfahren wurde für verschiedene Lebensmittelgruppen, wie z.B. Fleisch- und Fischerzeugnisse, Milchprodukte und Käse, Salate, Feinkost- und Convenience-Produkte erfolgreich getestet. Die Nachweisgrenze liegt bei < 20 KbE/g.
Der Nachweis der Bakterien basiert bei der neuen 6h-Schnellmethode „TentaSpeed L. mono“ wie bei der 24h-Methode auf der RT-PCR. Allerdings werden bei dieser Schnellmethode vor der Detektion mehrere Arbeitsschritte zur Aufkonzentration der Bakterien durchgeführt.
Dem BAV INSTITUT ist hiermit ein Durchbruch gelungen, da erstmals Ergebnisse von Listeria spp. und Listeria monocytogenes in Lebensmitteln innerhalb weniger Stunden vorliegen.
Haben Sie Fragen oder wünschen Sie ein Angebot? Kontaktieren Sie unseren Experten!
Die Tentamus Group wurde 2011 gegründet und ist ein globales Labor- und Servicenetzwerk, mit den Schwerpunkten in Europa, China, Japan, Indien und den USA. Akkreditiert und lizensiert testet, auditiert und berät Tentamus alle Bereiche, die mit dem Menschen zusammen hängen (Lebens- und Futtermittel, Pharmazeutika und Arzneimittel, Agrochemikalien, Kosmetika, Umwelt und Landwirtschaft sowie Nahrungsergänzungsmittel). Das Unternehmen ist global an über 65 Standorten mit mehr als 2.500 Mitarbeiterinnen und Mitarbeitern tätig.
Tentamus Group
An der Industriebahn 5
13088 Berlin, Germany
www.tentamus.com
Tentamus Group GmbH
An der Industriebahn 5
13088 Berlin
Telefon: +49 (30) 206038-230
Telefax: +49 (30) 206038-190
http://tentamus.com
Geschäftsführer BAV Institut
Telefon: 0781 96947 15
E-Mail: paul.andrei@bav-institut.de
![]()